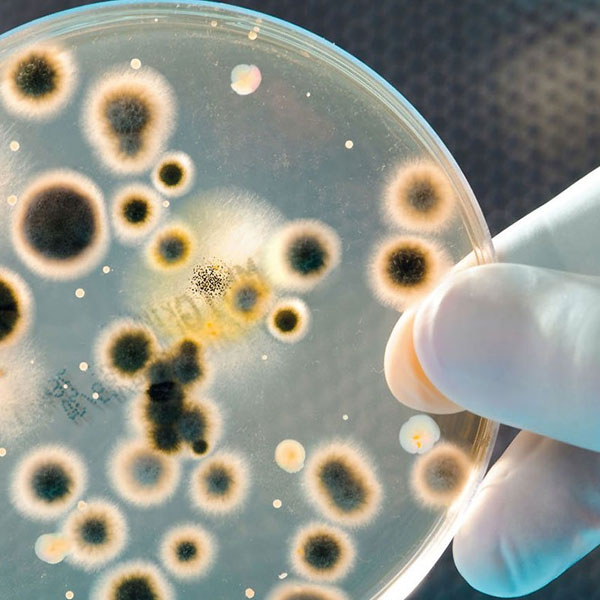
services-MICROBIOLOGY

We have 26+ Years In Laboratory Experiences
Trusted Laboratory Service Provider
With the use of state of the art equipment we ensure that all results are accurate to industry standards and delivered to all Medical Aid Companies, Doctors and Patients with 24 hour period of receipt of test requests. Results are emailed, sent via SMS, and hand delivered. Results are backed up on our servers should there be any future queries. Proteus Laboratories is committed to delivering quality results to our patients, doctors and medical aid schemes. We ensure professionalism and confidentiality in handling of all patients results in a timely manner. Currently servicing Gauteng area Pretoria (Mabopane) and Ekurhuleni (Springs, Kwa—Thema, Daveyton, Tsakane, Duduza and Germiston) Mpumalanga (Witbank ).
J G Kubheka
We Have World Class Professional Laboratory Equipment.
With the use of state of the art equipment we ensure that all results are accurate to industry standards and delivered to all Medical Aids Companies, Doctors and Patients with 24 hour period of receipt of test requests. Results are emailed, sent via SMS, and hand delivered. Proteus Laboratories is committed to delivering quality results to our patients, doctors and medical aid schemes.